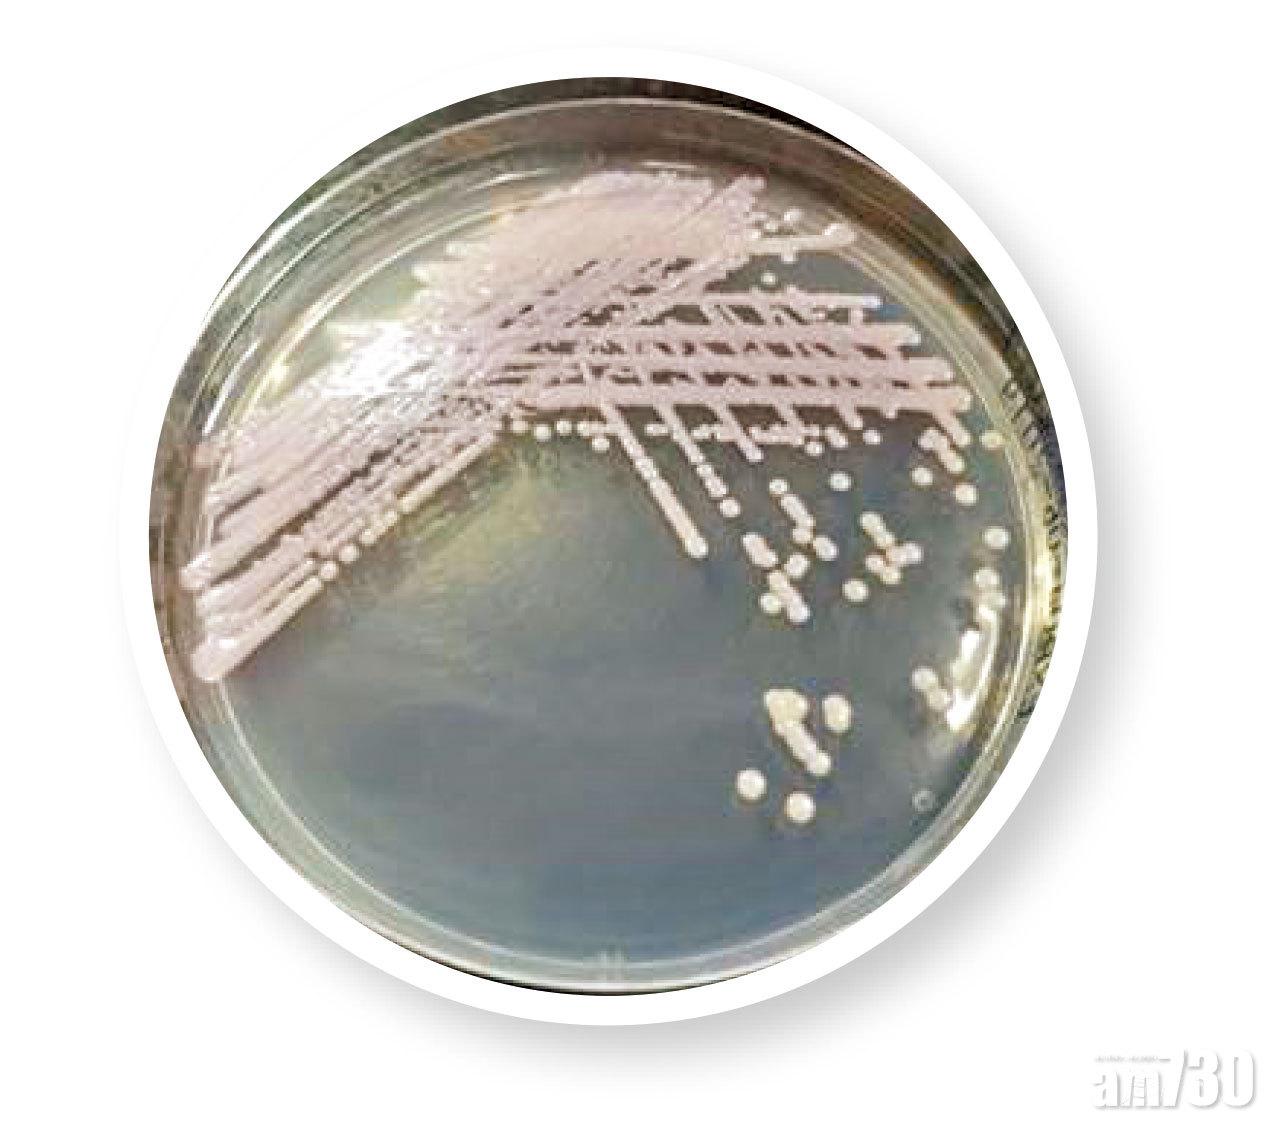

本港自6月至今已發現16人屬耳念珠菌帶菌者,經跟進調查後,全部只屬帶菌者並無受到感染,而直至現時已全部不再帶菌。醫管局形容,所有個案已經「完結」,但由於該菌容易在醫療環境中傳播,會加強醫院防控措施,包括加強實驗室檢測到物種水平及加強入院篩查。

賴偉文指,耳念珠菌(小圖)能存活於惡劣環境。
(小圖)
耳念珠菌是一種真菌,屬念珠菌一類,於2009年首次在日本一名病患者身上發現,此菌近年擴散至全球,大多在醫院和安養院。醫院管理局總感染控制主任賴偉文指,念珠菌常見於人類口腔、消化道、皮膚及女性陰道。耳念珠菌能夠長期存活在患者、醫護人員的皮膚表面以及醫院設施表面,在醫院環境存活可長達數星期,英國倫敦有醫院的深切治療部出現爆發情況,有四成病人被感染。

九成耳念珠菌具抗藥性
他指出,雖然用作治療耳念珠菌感染的藥物,基本上與現時普遍用作治療嚴重真菌感染的抗真菌藥無異,但九成耳念珠菌對最少一種抗真菌藥具抗藥性,更能抵抗一般消毒劑。健康的人帶耳念珠菌不會致病,但一旦感染,死亡率可達三至六成。
自6月至今,香港有16人證實屬帶菌者,全部無感染徵狀,首2名病人分別曾到瑞士及美國,相信屬外地輸入的個案,首7名帶菌者全在瑪嘉烈醫院出現。賴指,醫管局已為他們作基因排列,發現屬於同一品種(南亞演化支),相信來自同一源頭。

他又稱,所有個案已全部通過環境樣本測試和追查追蹤測試,包括病人用過的床欄、枱等,以及隔離後2至4星期間進行3次檢驗均呈陰性反應,相信現時本港個案已經「完結」。他重申,由於耳念珠菌能存活於惡劣環境(如乾燥及塑膠表面),加上在醫院較易傳播,不排除香港將來仍有爆發風險。
賴偉文透露,帶有侵入性導管或醫療儀器、患糖尿病、短期內曾接受手術或正服用寬廣譜抗生素或抗真菌素,均屬感染耳念珠菌的高危因素;防範勝於未然,醫管局現時已展開一系列感染控制措施,包括對入住深切治療部、臨床腫瘤科及血科等高危病房,以及過去一年曾在海外入院的病人進行入院篩查。

鑑於現時一般標準實驗室設備只能識別至「念珠菌」,實驗室須用「MALDI-TOF MS」蛋白質譜分析儀才能成功識別「耳念珠菌」。醫管局現時具備該分析儀,未來會加強檢測鑑定物種水平,以便能從一般念珠菌中辨識到耳念珠菌;萬一再在病房發現有帶菌者,院方亦對過去一個月與帶菌者共用房間或病格的病人展開追蹤篩查,減低病菌蔓延機會。
















